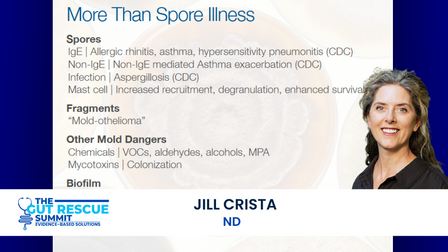

SAVE 97% OFF ON THIS PAGE ONLY
40+ Evidence-Based Presentations.
Zero Guesswork.

The Gut Rescue Summit brings together the researchers, clinicians, and specialists who are actually moving gut science forward—so you can stop sifting through conflicting advice and start making decisions based on what the research actually shows.
Own The Gut Rescue Summit
The free premiere gave you access to each day's sessions for 24 hours.
But gut healing isn't linear. The session you need six months from now might not be the one you need today. A symptom shifts, a treatment stalls, a new question emerges—and suddenly that masterclass on biofilms or vagus nerve stimulation becomes exactly what you're looking for.
The All-Access Pass puts all 40+ evidence-based masterclasses in your personal health library. Permanently.

What's Included:
Ongoing Access to All 40+ Masterclasses
Stream anytime. Return whenever you need a refresher or face a new challenge.
Slide Decks
The actual slides from each presentation—including the research citations and protocols our speakers reference.
NEW! Answers without watching every video (gasp)
Just ask. Smart Search pulls the exact answer from the videos, transcripts and slides—so you don't have to hunt. ($99 value)
Audio Files
Listen on your commute, during a walk, wherever works for you.
The Studies
Direct access to 500+ published research referenced throughout the summit. No more hunting down citations.
BONUS 1: SIBO Research Update - Dr. Mark Pimentel's Latest Update
The latest findings from one of the world's leading SIBO researchers—what's changed, what's coming, and what it means for your treatment.
BONUS 2: How the mBiota Elemental Diet Achieved 100% Hydrogen SIBO Success Rates Dr. Ali Rezaie, Shivan Sarna, and Dr. Allison Siebecker
A deep-dive conversation on microbiome testing and clinical application you won't find anywhere else.
BONUS 3: 15% off over 20,000+ professional-grade supplements with doctor recommendations
Access to a curated dispensary with doctor recommendations—so you're not guessing which brands or formulations to trust.
You've read the articles. You've tried the protocols. You've Googled symptoms at 2am wondering if this is SIBO or something else entirely.
And yet—you're still piecing it together yourself.
The Gut Rescue Summit is different. Every session is a masterclass built on published research, clinical data, and real-world results. No fluff. No "this worked for me so it might work for you." Just the science—translated into action steps you can actually use.
Masterclasses
20 are Masterclass presentations. They are structured 30-minute deep dive conference level sessions —complete with slides, research citations, and specific protocols. The kind of information practitioners pay to access at medical conferences. Now it's yours.
Evidence Over Anecdote
150 studies. Every speaker was asked to ground their session in published research and clinical data.
Curated, Not Crowded
40+ sessions sounds like a lot. I know you’re busy. But wasting your time is my kryptonite.
I spent months identifying the researchers and clinicians who are actually advancing gut health—then worked with each one to create a session that delivers real value. No filler. No fluff. Every talk earns its place.
Built For Your Library, Not Your Calendar
You don't need to watch everything live. You don't need to take a week off work. This summit is designed to meet you where you are—watch what's relevant now, save the rest for when you need it.
Some sessions will shift your understanding immediately. Others you'll return to six months from now when a new symptom appears or a treatment stops working.
This is a resource to support you. Not a deadline to stress you.
The question isn't whether you have time to watch 40+ presentations this week.
The question is... do you want access to this level of information to move you forward when you need it?
Free Summit Access
Action Package
Access to the free 7-Day premiere
✅
✅
Unlimited access to all 40+ presentations
❌
✅
Answers without watching every video or studying every slide - Just ask. Use the Smart Search for the exact answer from the videos and slides—so you don't have to hunt.
❌
✅
Transcripts (searchable with links to studies)
❌
✅
Links to the scientific studies referenced in the presentations
✅
Audio files to listen to the in-depth recordings on-the-go
❌
✅
The Gut Rescue Summit exists because I spent years doing exactly what you're doing—searching, testing, hoping. I know how exhausting it is to be your own researcher, advocate, and guinea pig all at once.
So I did the work for you if ...
You've been managing gut symptoms for months or years—and you're tired of trial and error.
You've tried elimination diets, probiotics, antimicrobials, maybe even prescription treatments—and something helped, but nothing resolved it.
You've done your own research, but the more you read, the more contradictory it gets. One expert says eat fiber. Another says avoid it. One protocol worked for someone online but made you worse.
You want real answers—not influencer opinions or oversimplified advice that ignores the complexity of what's actually happening in your body.
You're looking for information you can trust. Studies. Data. Clinical experience. Not just "this worked for me."
You don't have time to wade through hundreds of hours of content hoping something applies to you. You need it filtered. Curated. Relevant.
You want to build a personal health library—resources you can return to when you need them, not another thing demanding your attention right now.

No more trial and error or relying on anecdotal evidence; this is your opportunity to dive deep into what the science really says about healing your gut.
From breakthrough dietary insights to cutting-edge protocols and holistic lifestyle tools, we've curated a comprehensive week of talks that will equip you with proven strategies to finally fix your gut for good.
"Loving the Summit! Amazing modalities that a lot of people do not know that have helped me in my healing journey. I use the products in my practice that she mentioned it in the interview."
Margo
⭐⭐⭐⭐⭐
"Shivan Sarna! Thank you so much for such an informative and important summit! So much very useful and timely information. The quality of content and overall as always [is] superb! Needless to say, very grateful to you for everything you do for the community."
Beth
⭐⭐⭐⭐⭐
"As a layperson, some of the topics are going deeper than I need at this moment, but I will save for reference as I work with my doctor, so far really amazing information. Thank you for creating and sharing the summit!"
Georgia
⭐⭐⭐⭐⭐


Shivan Sarna
I’m Shivan Sarna, founder of SIBO SOS®, patient advocate, author of Healing SIBO. After suffering with SIBO symptoms for decades, I was finally diagnosed in 2015. After a lifetime of digestive problems, I was diagnosed with SIBO (Small Intestine Bacterial Overgrowth) in 2015. I was so excited to finally have a name for the symptoms that made me miserable – but I was quickly very frustrated by how hard it was to get access to reliable SIBO information, or even an appointment with a doctor who had experience treating SIBO. I set out to get answers about SIBO for myself – but along the way, I met hundreds (and then thousands) of other people like you who had the same problems: How do we find experts who really understand SIBO? What do we do if we can’t travel to see one of these experts? Will we have to suffer forever?
I am the author of Healing SIBO (20,000 copies sold!), a TV host and the creator of the SIBO SOS® Summits and Community, the Digestion SOS™ documentary series, the Gut & Microbiome Rescue Summit, the Liver and Gallbladder Rescue Summit, the Lymphatic Rescue Summit, the Dental Health Connection Summit, the Fascia and Chronic Pain Rescue Summit, and Chronic Condition Research, a 501(c)(3) non-profit to further research under-funded medical conditions.
After a lifetime of struggling with health issues, I made it my mission to demystify my health struggles to share that information with others who are struggling. My personal mantra is “SOS: Save Our Selves.” - that's what has helped thousands of people do!
Get all the time you need to watch and reference these invaluable resources for the rest and best of your life.

- 40+ expert presentations - Ongoing digital access to all session recordings ($59 each x 46 presentations = total value $2756)
- Answers without watching every video or studying every slide - Just ask. Smart Search pulls the exact answer from the videos and slides—so you don't have to hunt. ($99 value)
- The information-packed presentation slides ($99 value)
- The studies reference ebook with links to over 500+ cited studies ($99 value)
- 15% off over 20,000+ professional-grade supplements with doctor recommendations
- BONUS: How the mBiota Elemental Diet Achieves 100% SIBO Success Rates with Dr. Ali Rezaie
- BONUS: 2026 Research Update: Evolving Understanding of SIBO, IMO, and IBS with Dr. Mark Pimentel (priceless)
Total Value $3053 - that is 92% off!

For your security, all orders are processed on a secured server.

Proven Solutions to Detox, Defend & Repair After Pesticide Exposure
Isaac Eliaz, MD, MS, LAc

SIBO: The #1 Underlying Cause of IBS
Allison Siebecker, ND, MSOM, LAc

Overcoming the Top Blocks to Healing: Lymph and Liver Stagnation
Sinclair Kennally, CNHP, CNC
Get ongoing, on-demand access, including slide decks and searchable transcripts!

The T.I.G.E.R Protocol: The Solution to the Epidemic of Chronic Disease
Akil Palanisamy, MD

Manage Your Gut Conditions and Personalize Your Diet Plans in Just One Breath
Claire Shortt, PhD

Digestive Enzymes: New Science for a Better Gut and Food Tolerance
Steven Wright

Your Mouth Matters: Unraveling the Intricate Connection Between Oral Microbiota and Gut Health
Haroldo Magarinos, ND, DDS

Vibrating Capsules: A New Technology That Can Revolutionize Gut Health
Satish Rao, MD, PhD
Get ongoing, on-demand access, including slide decks and searchable transcripts!

Beyond Allergies: Understanding Mast Cell Activation and Histamine Dynamics
Christine Schaffner, ND

Adhesions and SIBO: Is This the Missing Root Cause of Your Chronic Gut Symptoms?
Larry Wurn, LMT

How Mycotoxins Create Digestive, Neuropsychiatric and Marriage Issues
Evan Brand, BCHN, FNTP

#2 Inside Fatty Liver Wellness: Symptoms and Root Causes Explored
Anne Hill, ND

#2 The Gut’s Hidden Enemy: Tough SIBO Causes, Symptoms and Solutions
Allison Siebecker, ND, MSOM, LAc

Is Your Brain in Flames? Fear, Fatigue and Brain Fog
Jenny Tufenkian, ND

Low Dose Naltrexone: Reduce Inflammation, Allergic Responses and Mast Cell Activation (MCAS)
Leonard Weinstock, MD, FACG
Get ongoing, on-demand access, including slide decks and searchable transcripts!

Bridging the Gap: Gut Health's Role in Fighting Metabolic Disorders
Kiran Krishnan

#1 Decoding Biofilms: Key to Unlocking Gut Health Secrets
Ilana Gurevich, ND, LAc, MSOM

#1 Fatty Liver Reversal: Strategies and Solutions for Effective Fatty Liver Treatments
Anne Hill, ND

Metabolic Syndrome and Gut Health Strategies for Reversing Chronic Diseases
Alicia Galvin, MEd, RD, LD, IFNCP
Get ongoing, on-demand access, including slide decks and searchable transcripts!

#2 Transforming Gut Health: Breakthrough Approaches to Outsmart Biofilms
Ilana Gurevich, ND, LAc, MSOM

Is Your Tail Talking? Approaches to Common Anorectal Disorders
Crane Holmes, ND

Heal Your Gut for Good: Introducing Methods to Heal and Seal the Gut
Jaban Moore, DC

How to Implement Game-Changing Strategies for Improved Gut Health
Sharon Stills, NMD

Reclaiming Digestive Wellness: Strategies for Restoring Gut Health Post-COVID
Margaret Christensen, MD, FACOG, IFMCP, ABOIM

How to Stimulate Your Vagus Nerve for Better Gut Health
Nicole DiNezza, DC, NTP
Get ongoing, on-demand access, including slide decks and searchable transcripts!

Heartburn: Understanding and Treating Its Root Causes
Steven Sandberg-Lewis, ND, DHANP

The Elemental Diet: A Powerful Tool for Healing the Gut
Roy Steinbock, MD & Debbie Steinbock

Microbiome
Restoration After
Acute and Long-Term Antibiotic Exposure
Sarah Ellis, ND, MS
Due to the digital nature of this summit and the fact that all materials become accessible immediately upon purchase, all sales are final. No refunds, cancellations, or exchanges will be issued for any reason. By completing your purchase, you acknowledge and agree to these terms, here. The information provided on this Site by Chronic Condition Rescue Coalition (CCRC) is not intended to diagnose, treat, cure, or prevent any disease, condition, or injury. It is for informational purposes only and represents the presenter(s)’ opinion(s) based on experiences and reviews of various sources related to the subject matter. CCR does not engage in the practice of medicine, psychiatry, psychology, counseling, or social work, nor do we offer healthcare, mental health, legal, financial, or other such services. CCR makes no guarantees or promises about the results you may achieve by applying the information you learn through this Site. Any reference to past results achieved by others does not constitute a guarantee or assurance that you will be able to obtain similar results. Always seek the advice of your physician or other qualified health provider regarding any specific health, medical, or mental health condition you may have before following the recommendations of anyone else, including us. You are personally responsible for your own medical, health, and mental health decisions, including how you may apply the information you obtain through this Site. CCRC expressly disclaims responsibility for any action you may take based on the information presented on our Site. CCRC makes reasonable efforts to provide accurate information; however, we do not make any warranties or representations regarding the accuracy, validity, or reliability of any information presented on our Site. All materials, video, audio, written transcript and course content including but not limited to copyrights, patents, trademarks, service marks, trade names and all other intellectual property rights (“IP Rights”) are owned by (CCRC) or our licensors and are protected by applicable US and international copyright and other intellectual property laws. You do not have, nor are entitled to claim, any rights in and to content and/or any portion thereof except as granted in these Terms. Our content may not be copied, distributed or transmitted in any way without prior written consent of Shivan Sarna of CCRC. Any unauthorized use of any such information or materials may violate copyright laws, trademark laws, laws of privacy / publicity, and other laws and regulations.
© 2026 Chronic Condition Rescue Coalition

SAVE 97% OFF ON THIS PAGE ONLY